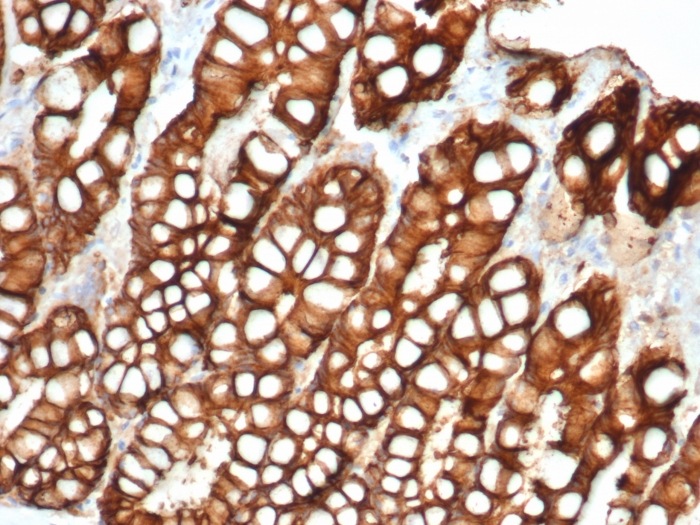
Formalin-fixed, paraffin-embedded feline (cat) small intestine stained with Ep-CAM Mouse Monoclonal Antibody (EGP40/1372). EpCAM Antibody in Immunohistochemistry (IHC (P))

Immunofluorescence analysis of MCF-7 cells. EpCAM-Monospecific Mouse Monoclonal Antibody (EGP40/1372) labeled with CF488 (green). Nuclei are stained with RedDot (red).

Formalin-fixed, paraffin-embedded Human Ovarian Carcinoma stained with EpCAM Mouse Monoclonal Antibody (EGP40/1372) conjugated to HRP.

Formalin-fixed, paraffin-embedded human colorectal carcinoma stained with EpCAM-Monospecific Mouse Monoclonal Antibody (EGP40/1372).

Formalin-fixed, paraffin-embedded human hepatocellular carcinoma stained with EpCAM-Monospecific Mouse Monoclonal Antibody (EGP40/1372).

Flow Cytometric Analysis of PFA-fixed MCF-7 cells using EpCAM-Monospecific Mouse Monoclonal Antibody (EGP40/1372) followed by goat anti-mouse IgG-CF488 (blue); isotype control (red).

Confocal immunofluorescence of human colorectal carcinoma. EpCAM-Monospecific Mouse Monoclonal Antibody (EGP40/1372) labeled with CF488 (green); Nuclei are labeled with Reddot (red).

Analysis of Protein Array containing >19,000 full-length human proteins using EpCAM Mouse Monoclonal Antibody (EGP40/1372). Z- and S- Score: The Z-score represents the strength of a signal that a monoclonal antibody (MAb) (in combination with a fluorescently-tagged anti-IgG secondary antibody) produces when binding to a particular protein on the HuProtTM array. Z-scores are described in units of standard deviations (SD's) above the mean value of all signals generated on that array. If targets on HuProtTM are arranged in descending order of the Z-score, the S-score is the difference (also in units of SD's) between the Z-score. S-score therefore represents the relative target specificity of a MAb to its intended target. A MAb is considered to specific to its intended target, if the MAb has an S-score of at least 2.5. For example, if a MAb binds to protein X with a Z-score of 43 and to protein Y with a Z-score of 14, then the S-score for the binding of that MAb to protein X is equal to 29.

Formalin-fixed, paraffin-embedded canine (dog) bladder stained with Ep-CAM Mouse Monoclonal Antibody (EGP40/1372).
Formalin-fixed, paraffin-embedded feline (cat) small intestine stained with Ep-CAM Mouse Monoclonal Antibody (EGP40/1372).
EGP40 is a 40-43kDa transmembrane epithelial glycoprotein, also identified as epithelial specific antigen (ESA), or epithelial cellular adhesion molecule (Ep-CAM). It is expressed on baso-lateral cell surface in most simple epithelia and a vast majority of carcinomas. This antibody has been used to distinguish adenocarcinoma from pleural mesothelioma and hepatocellular carcinoma. This antibody is also useful in distinguishing serous carcinomas of the ovary from mesothelioma.
There are no reviews yet.